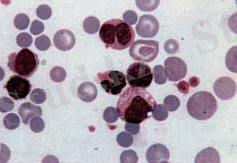

Жылқының инфекциялық анемиясы: қоздырғыштары, патогенезі, клиникалық белгілері, диагностикасы және профилактикасы


Жылқының инфекциалық анемиясы.
Жоспары:
- Кіріспе:
1. 1 Ауру туралы түсінік
1. 2 Тарихы, анықтамасы, таралуы, қауіптілік дәрежесі және зардабы.
- Негізгі бөлім:
2. 1 Ауру қоздырғыштар
2. 2 Эпизоотология
2. 3 Патогенез
2. 4Клиникалық көрінісі
2. 5 Патологиялық анатомиялық көрінісі
2. 6 Диагностика және ажырату диагностикасы
2. 7 Иммунитет, арнамалы алдын-алу
2. 8 Емі
- Корытынды: Профилактика
- Әдебиеттер тізімі
Жылқының инфекциалық анемиясы - ( лат. - Anemia infectiosa eguorum ; агылш. - Eguine infectious anemia ; ) қан жасаушы мүшелердің зақымдалуымен жүретін патология. Көбінесе, мүшелердегі іріңді ошақтардың, ұзаққа созылатын қайталанбалы қызбамен, геморрагиялық диатезбен, ЭТЖ төмендеуімен жүреді. Қан құрамындағы гемоглобин, эритроциттерді азайтып, жануарды бірден әлсіретуге әкелетін патология. Вирустары организмде ұзақ уақыт сақталып, тасымалданады.
Тарихта осы патология туралы өте көп деректер кездеседі. Солардың ішінде құндылары.
1843 жылы ең алғаш рет ЖИА туралы фр. мал дәрігері Франции Лигаей сипаттап жазған.
1859 жылы Ангиннард инфекциялық анемияны сау жылқыға ауру малдың қанын тікелей қанға енгізу арқылы жұғатынын ғылыми тұрғыдан дәлелдеген.
1904 жылы Карре мен Балле -ауру қоздырғышы вирус екенін дәлелдеген. Вирус жұқтырғын малда, инфекция қан мен мүшелерінде ұзақ сақталатынын дәлелдеп жазған.
1969 жылы Кон вирусты лейкоциттен бөліп алған.
1910 жылы ең алғаш рет Ресейде Помудин жылқыда кездесетін инфекциялық ауру туралы жазған.
1932 жылы Я. Е. Коляков алған ЖИА-ның диагностикалық әдісін ойлап тапты.
Жылқының инфекциялық анемиясы бірінші әне екінші дүние жүзлік соғыс кездерінде өте көп кездесті. Соңғы жылдары МЭБ зерттеуі бойынша патология АҚШ, Австралия, Жапония, Үндістан, Африка, Ресей елдерінде кездесіп отыр.
Жылқының инфекциялық анемиясы жылқы шаруашылығымен айналысатын елдердің экономикасы үлкен залал болып тұр. Дүние жүзілік статистикаға жүгінсек біріншілік ауру тараған кездегі өлім-жетім көрсеткіші 80% құраған. Инфекциялық анемия диагностикасы елге экономикасы көп шығынды талап етеді, сондықтан профилактикалық жұмыстарды күшейту керек.
Ауру қоздырушылар.
Ауру туғызушы вирус көбіне Retroviridae тұқымдастары. Сфералық формада, орташа диаметрі 90-120 нм. 2 қабатты сұлбамен қапталған РНК-лы вирус.
Жер бетінде өте көп таралған, ең жиі кездесетіні ЖИА-ның 411 штамды вирусы. Көбіне вирус құлындардың жасуларын зақымдап, организмде жасырын күйде өмір сүреді. Вирус химиялық факторларға өте тұрақтыз.
2 сағат бой 20% хлорлы әкте, 1% фенол ерітіндісінде және формалинде ұстасада өлемейді. 3 жыл бойы 0-2 0 С-та, 7 ай глицеринде, несеп пен көңде 2. 5 ай, залалсыздандырылған суда 160 күн, инфекцияланған жемде 9 ай, көңді биотермикалық өңдеседе 30 күнге дейін вирус өмір сүреді.
Тек 2-4 натрий гидрооксидінде 20 минут, 2% формалин ерітіндісінде 5 минут өмір сүреді.
Эпизоотология.
ЖИА-мен көбіне жылқылар, есектер, қашырлар аурады. Қоздырушы вирустар ауру малда ұзақ сақталып, жасырын күйінде 10 жылға дейін вирус тасымалдаушы бола алады. Ауру жылқыдан вирус секреттері арқылы бөлініп отырады: несеп, нәжіс, мұрын шырышы және сут. Вирусты таратушы факторлар: жем, су, көң. Негізгі вирустың таралу көзі - жанаспалы жол арқылы. Көбіне қансорушы жәндіктер:сона, маса, жигалок шыбыны. Қауіптісі - сона, оның сілекейінде вирус ұзақ уақыт сақталады. Сау жылқыға 0. 01 мл залалсыздандырылған қан арқылы тез жұғады. Ауру жаз айларында көп тіркеледі. Көбіне арқап, жайылым, орманды-сазды жерлердің жануарларында. Ауырған жылқылар үнемі ыстық, құрғақ жаз айларында бақылауда болады. ЖИА көбіне 3-5 айға созылады. Диагностикаға көбіне жедел, созылмалы, жасырын түрде ауыратын жануарлар алынады. Жануар көбіне вирустасымалдаушы.
Патогенез.
Вирус денеге тері және кілегейлі қабықтардан қансорушы жәндіктер арқылы енеді. Індеттің көктем мен жаз айларында тоғайлы, шалшық сулы жерлерде қаулап шығуын қансорушылардың жылдың сол мезгілдерінде өніп, өсулерімен байланыстыруға болады. Вирусқа эритротропизм тән, ол эриторциттермен бүкіл организмдерге тарайды, әсіресе гемопоэз және тамырлар жүйесінде шоғырланады. Вирус жұктырғаннан кейін 5 күн ішінде 1 мкл қанда эритроцит 1. 5-3 млн-ға дейін азайып, түстік көрсеткіш және гемоглобин 50% азаяды. 24 сағат ішінде ЭТЖ жоғарлайды. ЦПД қорытындысы бойынша организмде жасушалық антиген пайда болып, оған қарсы антидене түзіледі.
Клиникалық белгілері:
Аурудың негізгі белгісі мал температурасы көтеріліп, мезгіл-мезгіл безгектенуі. Бундай жағдай инфекциялық прцестің бастапқы белгісі. Аурудың жедел өршуінде мал темперасы 41 о С көтеріліп кейбір жағдайларда мал өлуіне дейін соқтырады. Ауырған мал температурасы ауытып отырады, әсіресе таңертеңгі температурадан м кешкі температурасы жоғары болады. Сондықтан жұқпалы анемияға сикем болған жағдайда әр күн шаруашылықтағы малдың дене температурасы 2 рет тексеріліп отырады. Зерттеу нәтижелері аурудың нозоологиялық бақылауда маңызды рөл атқарады.
Клиникалық көрініс 4 этаптан өтеді.
- Жеделше- дене температурасы бірден көтеріліп, геморрагиялық гастроэнтерит, тұншығу, журек шамасыздығы, 1-2 кун ішінде жануардың артқы аяғының салдануына әкеледі.
- Жедел- дене температурасы 41-42оС. Естен тану, жүрек-кантамырларындағы бұзылыс, арықтау, коньюктиваға қан құйылу, іштің ісінуі, жүрісінің шалынуы, ентікпе, анемияның тез туындауы. Қан су тәрізді сұйылып эритроцит саны азаяды 1 млн 1мкл дейін, гемоглобин 35-50 г/л төмендейді. ЭТЖ 70-80 мл көтеріледі. Ауру ұзақтығы 1-3 апта, кейде 1 айға созылуы мүмкін. Көп жағдайда жануар өледі.
- Жеделдеу- ұзақтығы 2-3 ай. Клиникалық көрінісі сақталады, кейде байқалмай, жануар сау көрінеді. Дене кызуынан жануар салданып өледі.
- Созылмалы- бірнеше айға созылады, жеделдеу сатысының жалғасы. Қызба алмасып қайталанады. Ентігу, тахикардия, әлсіздік, бұлшық ет құрысуы, арықтап жануар өледі.
- Жасырын кезеңі- Дене температурасы аз уақыт ішінде көтеріледі, жануар сау сияқты, бірақ вирустасымалдаушы. Ауру бірнеше жылға созылуы мүмкін. Қатты физикалық кушті көтере алмай жануар өледі.


Жұқпалы анемияда қан көрсеткіштерінің өзгеру мөлшері.
Патологиялық анатомиялық көрінісі.
Жануарға жасалған патологиялық сараптама нәтижесі.
- Арықтық, коньюктивада, мұрынның шырышты қабатында сары жолақтың пайда болуы
- Тері асты, бұлшық ет аралық жасушаларына қан құйылулар, серозды-геморрагиялық инфилтраттар.
- Лимфа, талақ, бауыр, жүрек ұлғаюы, қабық астына қан құйылулар.
- Миокард сүр тусті.
- Ішек-қарынның шырышты қабатына қан құйылулар.
Созылмалы сатысында :
- Ішек-қарын, коньюктива қабатына қан құйылулар
- Жүрек, талақ, лимфа түйіндерінің ұлғаюы
Жасырын кезеңінде ешкандай өзгеріс болмайды.
Гистологиялық тексеру.
Бауыр, талақта көп өзгеріс бар. Бауыр капиллярында гистиоцит, макрофит, лимфоид клеткалары кездеседі. Макрофаг Купфер жасушасында гемосидеринге, ал талақта жетілмеген эритроциттер көр кездеседі.

Ажырату диагностикасы.
ЖИА клиникалық жағынан бір-біріне ұқсас аурулармен ажыратылады. Олар: пироплазмоз, нутталлиоз, трипаносомоз, лептоспироз, ринопневмония, ішек құрты.
- Пироплазмоз- бұл мезгілдік ауру. Көбіне сәуір-мамыр, тамыз-қыркүйек айларында кездеседі. Ауру жедел басталады. Қан талдамасында эритроциттен- Piroplasma caballi анықталған.
- Нутталлиоз- мезгілдік ауру көбіне маусым айында кездеседі. Ауру жедел, жеделдеу және қте сирек созылмалы түрде кездеседі. Nuttallia equi паразитімен шақырылады. Дене қызуы 40-41оС, есеңгіреу, тәбет төмендеуі, пульс жиілеуі, ентігу, сарғаю, гемоглобин, эритроцит төмендеуі, ішек атониясымен жүреді. Шағылыстыру кезінде беріледі. Көбіне ерінде, мойында депигментациялар пайда болады.
- Трипаносомоз- көбінде шеткі қан-тамырларында анықталады. Жоғарғы дене қызуы, тері астылық жасушаның ісінуі, қаназдық. Шағылыстыру кезінде беріледі. Ауру қоздырушы (бірклеткалы қозғалмалы жіптәрізді паразит) иесінің қанында ұзына бойы бөлініп, көбейеді. Қансорғыш жәндіктермен және шағылыстыру кезінде жұғады.
- Лептоспироз- ауру жануардың қан сарысуын зеттегенде микро, макроагглютинацияның табылуы. Несеп, қан талдамасы, патанатомиясы өзгеріссіз.
- Ринопневмония- көбіне тыныс органдары зақымдалады.
- Ішек құрты- қызбасыз жүретін анемия. Көбіне копрологиялық талдама нәтижесінде аскорида анықталады.
Емі : Емі осы уақытта дейін дамымаған. Ауру малдың көзін жою.
Иммунитет: Ауру жылқының қанынан - фиксирлеуші, вируснейтралездеуші антиденелер табылған. Қазіргі таңда Францияда ЖИА қарсы вакциналар дайындалуда.
Профилактикалық шаралар.
- ЖИА-ның алдын алу
- Ауру малдың етін сатуға қатаң ветеринарлық бақылау жүргізу.
- Жылқыларға серологиялық зерттеу жүргізу РДП бойынша.
- Ауырған жылқыларды жою.
- Айына 2 рет дене қызуын өлшеу.
- Өлген жылқы етін жыртқыштар мен құстарға жем қылып беруге болады.
ЖИА диагнозы қойылғаннан кейін карантин жарияланады. Жылқыларды РДП бойынша серологиялық зерттеу жүргізу. Ауру жылқыларға 15 кун сайын карантин жариялап 4% натрий күйдіргіш қышқылмен залалсыздандыру. 3 ай сайын көңге биотермикалық өңдеу жүргізу. Гематофагпен күресу үшін инсектицид қолданылады. 3% креолинді жылқыларға бүрку. Әсер ету ұзақтығы 3-5 сағат.
Жылқының инфекциялық анемиясының алдын алу
және жою бойынша ветеринариялық ережелер
Осы Жылқының инфекциялық анемиясының алдын алуын және жою бойынша ветеринариялық ережелер (әрi қарай - Ветеринариялық ережелер) Қазақстан Республикасының "Ветеринария туралы" Заңының26 бабына сәйкес жеке және заңды тұлғалардың орындауға мiндеттi ветеринариялық шараларын ұйымдастыру және орындау тәртiбiн анықтайды.
1. Жалпы ережелер
1. Жылқының инфекциялық анемиясы тақ тұяқты жануарлардың, дене қызуының тұрақты немесе аумалы төкпелi қызбасымен, қан аздығымен, жүрек жүйесiнiң жұмысының бұзылуымен ерекшеленетiн вирустық ауру.
Табиғи жағдайда барлық жастағы жылқылар, есектер, қашырлар ауырады.
Көп жағдайда ауру созылмалы түрде өтедi. Жiтi және жiтiден төмен түрлерi сирек тiркеледi. Жұқпалы анемиямен ауырып жазылған жылқылар өмiр бойы вирус тасымалдаушы болып қалады.
Аурудың қоздырушысы негiзiнен қан сорғыш жәндiктер арқылы таралады.
2. Жылқының инфекциялық анемиясына диагноз клиникалық және патологоанатомиялық белгiлерiнiң, iндеттанулық деректер және зертханалық зерттеулердiң нәтижелерi негiзiнде қойылады.
2. Ветеринариялық-санитарлық таза аумақтағы
жылқының инфекциялық анемиясының алдын алу үшiн
жүргiзiлетiн шаралар
- Іс жүргізу
- Автоматтандыру, Техника
- Алғашқы әскери дайындық
- Астрономия
- Ауыл шаруашылығы
- Банк ісі
- Бизнесті бағалау
- Биология
- Бухгалтерлік іс
- Валеология
- Ветеринария
- География
- Геология, Геофизика, Геодезия
- Дін
- Ет, сүт, шарап өнімдері
- Жалпы тарих
- Жер кадастрі, Жылжымайтын мүлік
- Журналистика
- Информатика
- Кеден ісі
- Маркетинг
- Математика, Геометрия
- Медицина
- Мемлекеттік басқару
- Менеджмент
- Мұнай, Газ
- Мұрағат ісі
- Мәдениеттану
- ОБЖ (Основы безопасности жизнедеятельности)
- Педагогика
- Полиграфия
- Психология
- Салық
- Саясаттану
- Сақтандыру
- Сертификаттау, стандарттау
- Социология, Демография
- Спорт
- Статистика
- Тілтану, Филология
- Тарихи тұлғалар
- Тау-кен ісі
- Транспорт
- Туризм
- Физика
- Философия
- Халықаралық қатынастар
- Химия
- Экология, Қоршаған ортаны қорғау
- Экономика
- Экономикалық география
- Электротехника
- Қазақстан тарихы
- Қаржы
- Құрылыс
- Құқық, Криминалистика
- Әдебиет
- Өнер, музыка
- Өнеркәсіп, Өндіріс
Қазақ тілінде жазылған рефераттар, курстық жұмыстар, дипломдық жұмыстар бойынша біздің қор #1 болып табылады.



Ақпарат
Қосымша
Email: info@stud.kz